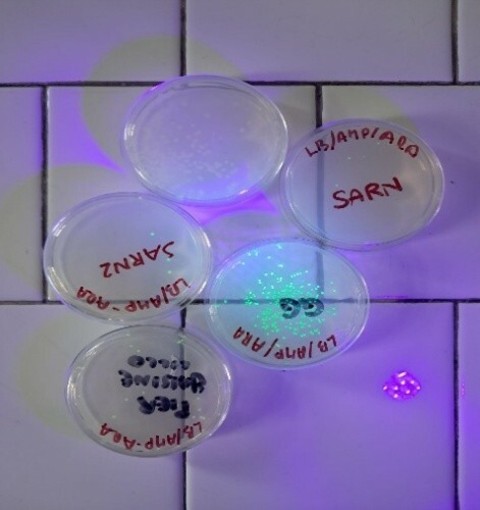
La scienza prende vita nei laboratori del Liceo Giolitti-Gandino di Bra

Riceviamo e pubblichiamo
***
Quando la ricerca si accende in laboratorio: batteri transgenici fluorescenti agli u.v.
La scienza non si studia soltanto:
si sperimenta
si osserva
si vive.
Nel percorso di potenziamento biomedico pomeridiano, i nostri studenti del triennio approfondiscono argomenti di chimica e biologia per affrontare con maggiore sicurezza i test di accesso alle facoltà scientifiche e sanitarie.
Quest’anno il progetto ha compiuto un ulteriore passo avanti.
Grazie ai laboratori innovativi potenziati con i fondi del Piano Nazionale di Ripresa e Resilienza, ottenuti dal Liceo “Giolitti-Gandino” con un impegnativo progetto promosso dal Dipartimento di Scienze, gli studenti possono partecipare a esercitazioni pratiche di ingegneria genetica, modificando il patrimonio genetico di batteri attraverso attività sperimentali guidate dai docenti.
Queste attività rappresentano un’opportunità straordinaria per sviluppare competenze scientifiche avanzate, acquisire metodo e rigore sperimentale, avvicinarsi concretamente alla ricerca biomedica
e orientarsi in modo più consapevole verso il proprio futuro.
Un’esperienza concreta di scienza “in azione” nel laboratorio che si “illumina” di ricerca: un primo vero passo dentro il mondo universitario e scientifico.
Il percorso si concluderà ad aprile con una visita al Museo di Anatomia Umana Luigi Rolando e al Museo di Antropologia Criminale Cesare Lombroso di Torino, per approfondire dal vivo lo studio dell’anatomia e della storia della scienza.
Formare studenti preparati, curiosi e pronti ad affrontare il mondo universitario, questa è la nostra priorità per permettere ai nostri ragazzi di fare un concreto passo nel mondo della ricerca
Il Liceo “Giolitti-Gandino” si conferma così una realtà dinamica e attenta all’innovazione, capace di coniugare tradizione liceale e apertura verso le sfide della scienza contemporanea.

!["Il territorio in tavola", dodici squadre di scuole alberghiere si sfidano ad Alba con Pera Madernassa, Robiola e Nocciola Piemonte [FOTO] "Il territorio in tavola", dodici squadre di scuole alberghiere si sfidano ad Alba con Pera Madernassa, Robiola e Nocciola Piemonte [FOTO]](https://www.targatocn.it/typo3temp/pics/41ba48e017.jpg)